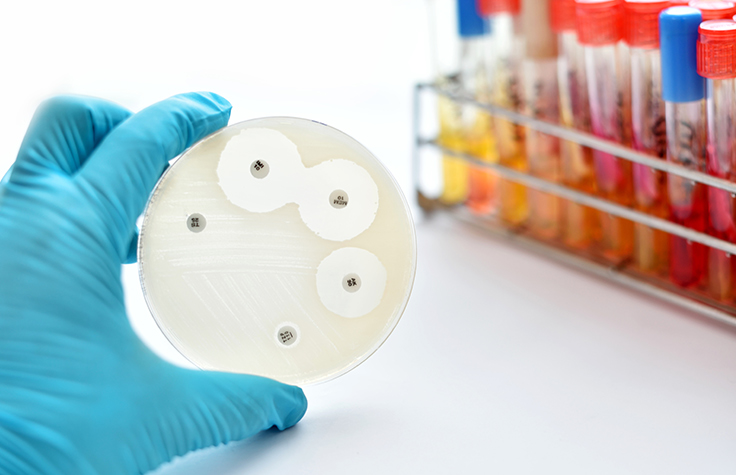

NGS and New Frontiers in Infectious Disease
The Illumina Genomics Podcast
NGS and New Frontiers in Infectious Disease
Sepsis is a serious medical condition typically caused by a bloodstream infection. The World Health Organization estimates that sepsis affects 30 million people worldwide every year, leading to 6 million deaths. Listen to Jean-François Brepson of PathoQuest discuss the challenges in infectious disease diagnostics and how NGS technology can improve pathogen detection and antibiotic stewardship.